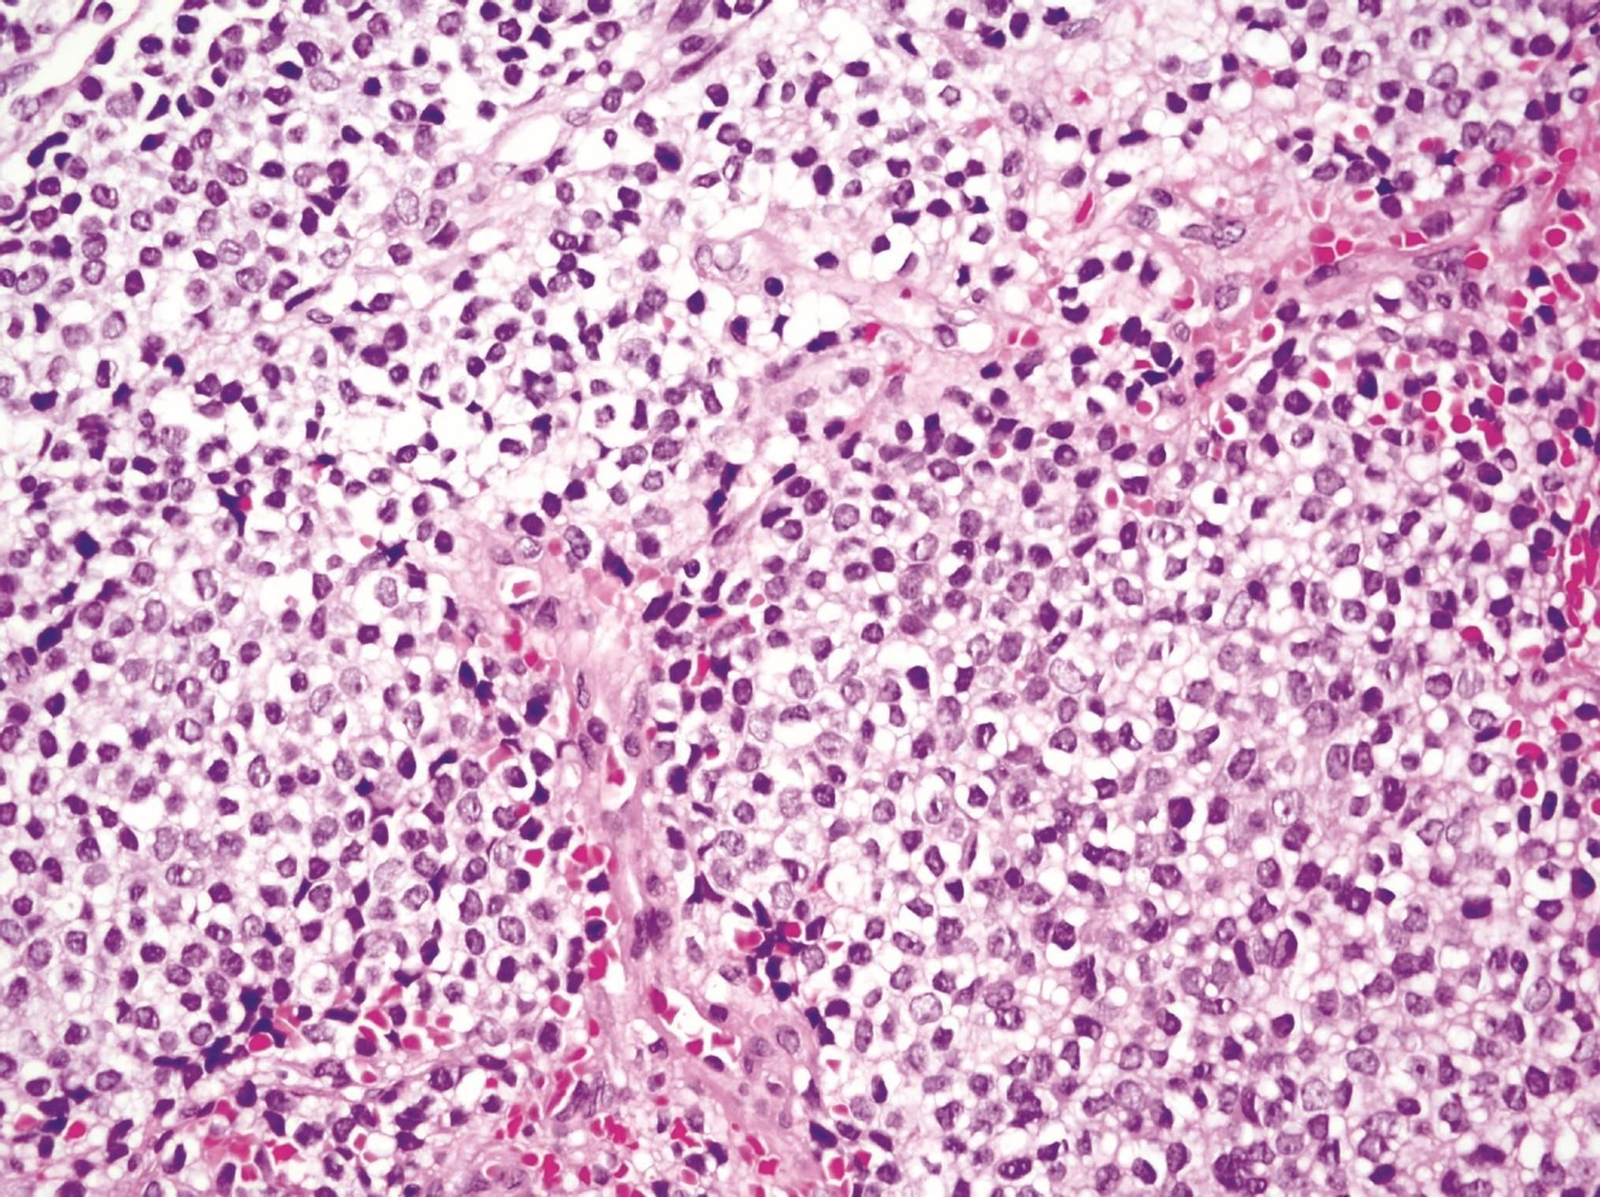
Sarcoma de Ewing

Un estudio del Instituto de Biomedicina de Sevilla desvela un nuevo mecanismo de sensibilidad del sarcoma de Ewing a la quimioterapia
La investigación, publicada en la revista Oncogene, muestra cómo una interacción molecular específica determina la eficacia del irinotecán en este tipo de tumor pediátrico
Un equipo del Instituto de Biomedicina de Sevilla (IBiS) ha identificado un nuevo mecanismo molecular que explica la elevada sensibilidad del sarcoma de Ewing —un tumor óseo agresivo que afecta principalmente a niños y adolescentes— a determinados fármacos quimioterápicos, como el irinotecán. Los resultados, publicados en la revista Oncogene, abren la puerta a estrategias más personalizadas y eficaces para el tratamiento de este tipo de cáncer.
El estudio ha sido liderado por los profesores Enrique de Álava y Fernando Gómez-Herreros, cuyos grupos han colaborado estrechamente dentro del IBiS. Ambos han codirigido la tesis doctoral José Joaquín Olmedo-Pelayo, primer autor del trabajo, que ha contado además con la participación de instituciones de referencia nacionales e internacionales
Un talón de Aquiles molecular
El sarcoma de Ewing está caracterizado por una alteración genética muy específica: la fusión de los genes EWSR1 y FLI1, que da lugar a una proteína quimérica oncogénica denominada EWS::FLI1. Esta fusión, además de iniciar y sostener el crecimiento tumoral, altera procesos celulares esenciales. En este estudio, los investigadores han descubierto que EWS::FLI1 secuestra a una proteína clave, DHX9, impidiendo su función natural en la resolución de algunas estructuras de ADN/ARN llamadas R-loops. Como consecuencia, las células tumorales acumulan estas estructuras, lo que conduce a inestabilidad genómica, estrés replicativo y muerte celular, especialmente tras el tratamiento con irinotecán, un inhibidor de la topoisomerasa I, que induce altos niveles de R-loops en la célula.
"Hemos identificado una vulnerabilidad específica del sarcoma de Ewing que se puede explotar terapéuticamente. Esta alteración en la maquinaria de resolución de R-loops no solo explica la sensibilidad al irinotecán, sino que también sugiere nuevas combinaciones terapéuticas con inhibidores de ATR que podrían mejorar la eficacia del tratamiento", explicó Fernando Gómez-Herreros, investigador del IBiS y coautor senior del estudio.
Aplicaciones clínicas
Además del valor biológico del descubrimiento, los hallazgos tienen un potencial clínico directo. En primer lugar, los investigadores han observado que niveles elevados de DHX9 se asocian a peor pronóstico, lo que plantea su uso como biomarcador predictivo de respuesta. En segundo lugar, bloquear la interacción entre EWS::FLI1 y DHX9, reduce la acumulación de daño genético y confiere resistencia al irinotecán, lo que refuerza la relevancia funcional de esta interacción.
"Este trabajo nos ayuda a entender por qué algunos pacientes con sarcoma de Ewing responden especialmente bien a fármacos como el irinotecán. Pero, sobre todo, nos da pistas para estratificar mejor a los pacientes y diseñar ensayos clínicos con terapias combinadas más racionales y dirigidas", afirmó Enrique de Álava, jefe del Servicio de Anatomía Patológica del Hospital Universitario Virgen del Rocío e investigador responsable del grupo Patología molecular de los sarcomas y otros tumores del IBiS. "En un tumor tan complejo y agresivo como este, ganar precisión en el tratamiento puede marcar una diferencia real en la supervivencia".
Colaboración y proyección
El estudio representa un ejemplo exitoso de colaboración multidisciplinar e interinstitucional. Junto a los grupos de Álava y Gómez-Herreros en Sevilla, han participado investigadores del CIBERONC, el Instituto de Salud Carlos III, el Hospital Sant Joan de Déu, el Instituto Valenciano de Oncología, la Universidad de Valencia, el German Cancer Research Center (DKFZ), el Hopp Children's Cancer Center en Heidelberg, el IRCCS Istituto Ortopedico Rizzoli de Bolonia y la Universidad de Heidelberg, entre otros.
Este proyecto ha sido posible gracias al Instituto de Salud Carlos III, Ministerio de Ciencia, Innovación y Universidades, Fundación científica de la Asociación española contra el cáncer, la Universidad de Sevilla, la Asociación Pablo Ugarte, La asociación La Sonrisa de Ale, y la Fundación María García Estrada.
También te puede interesar








